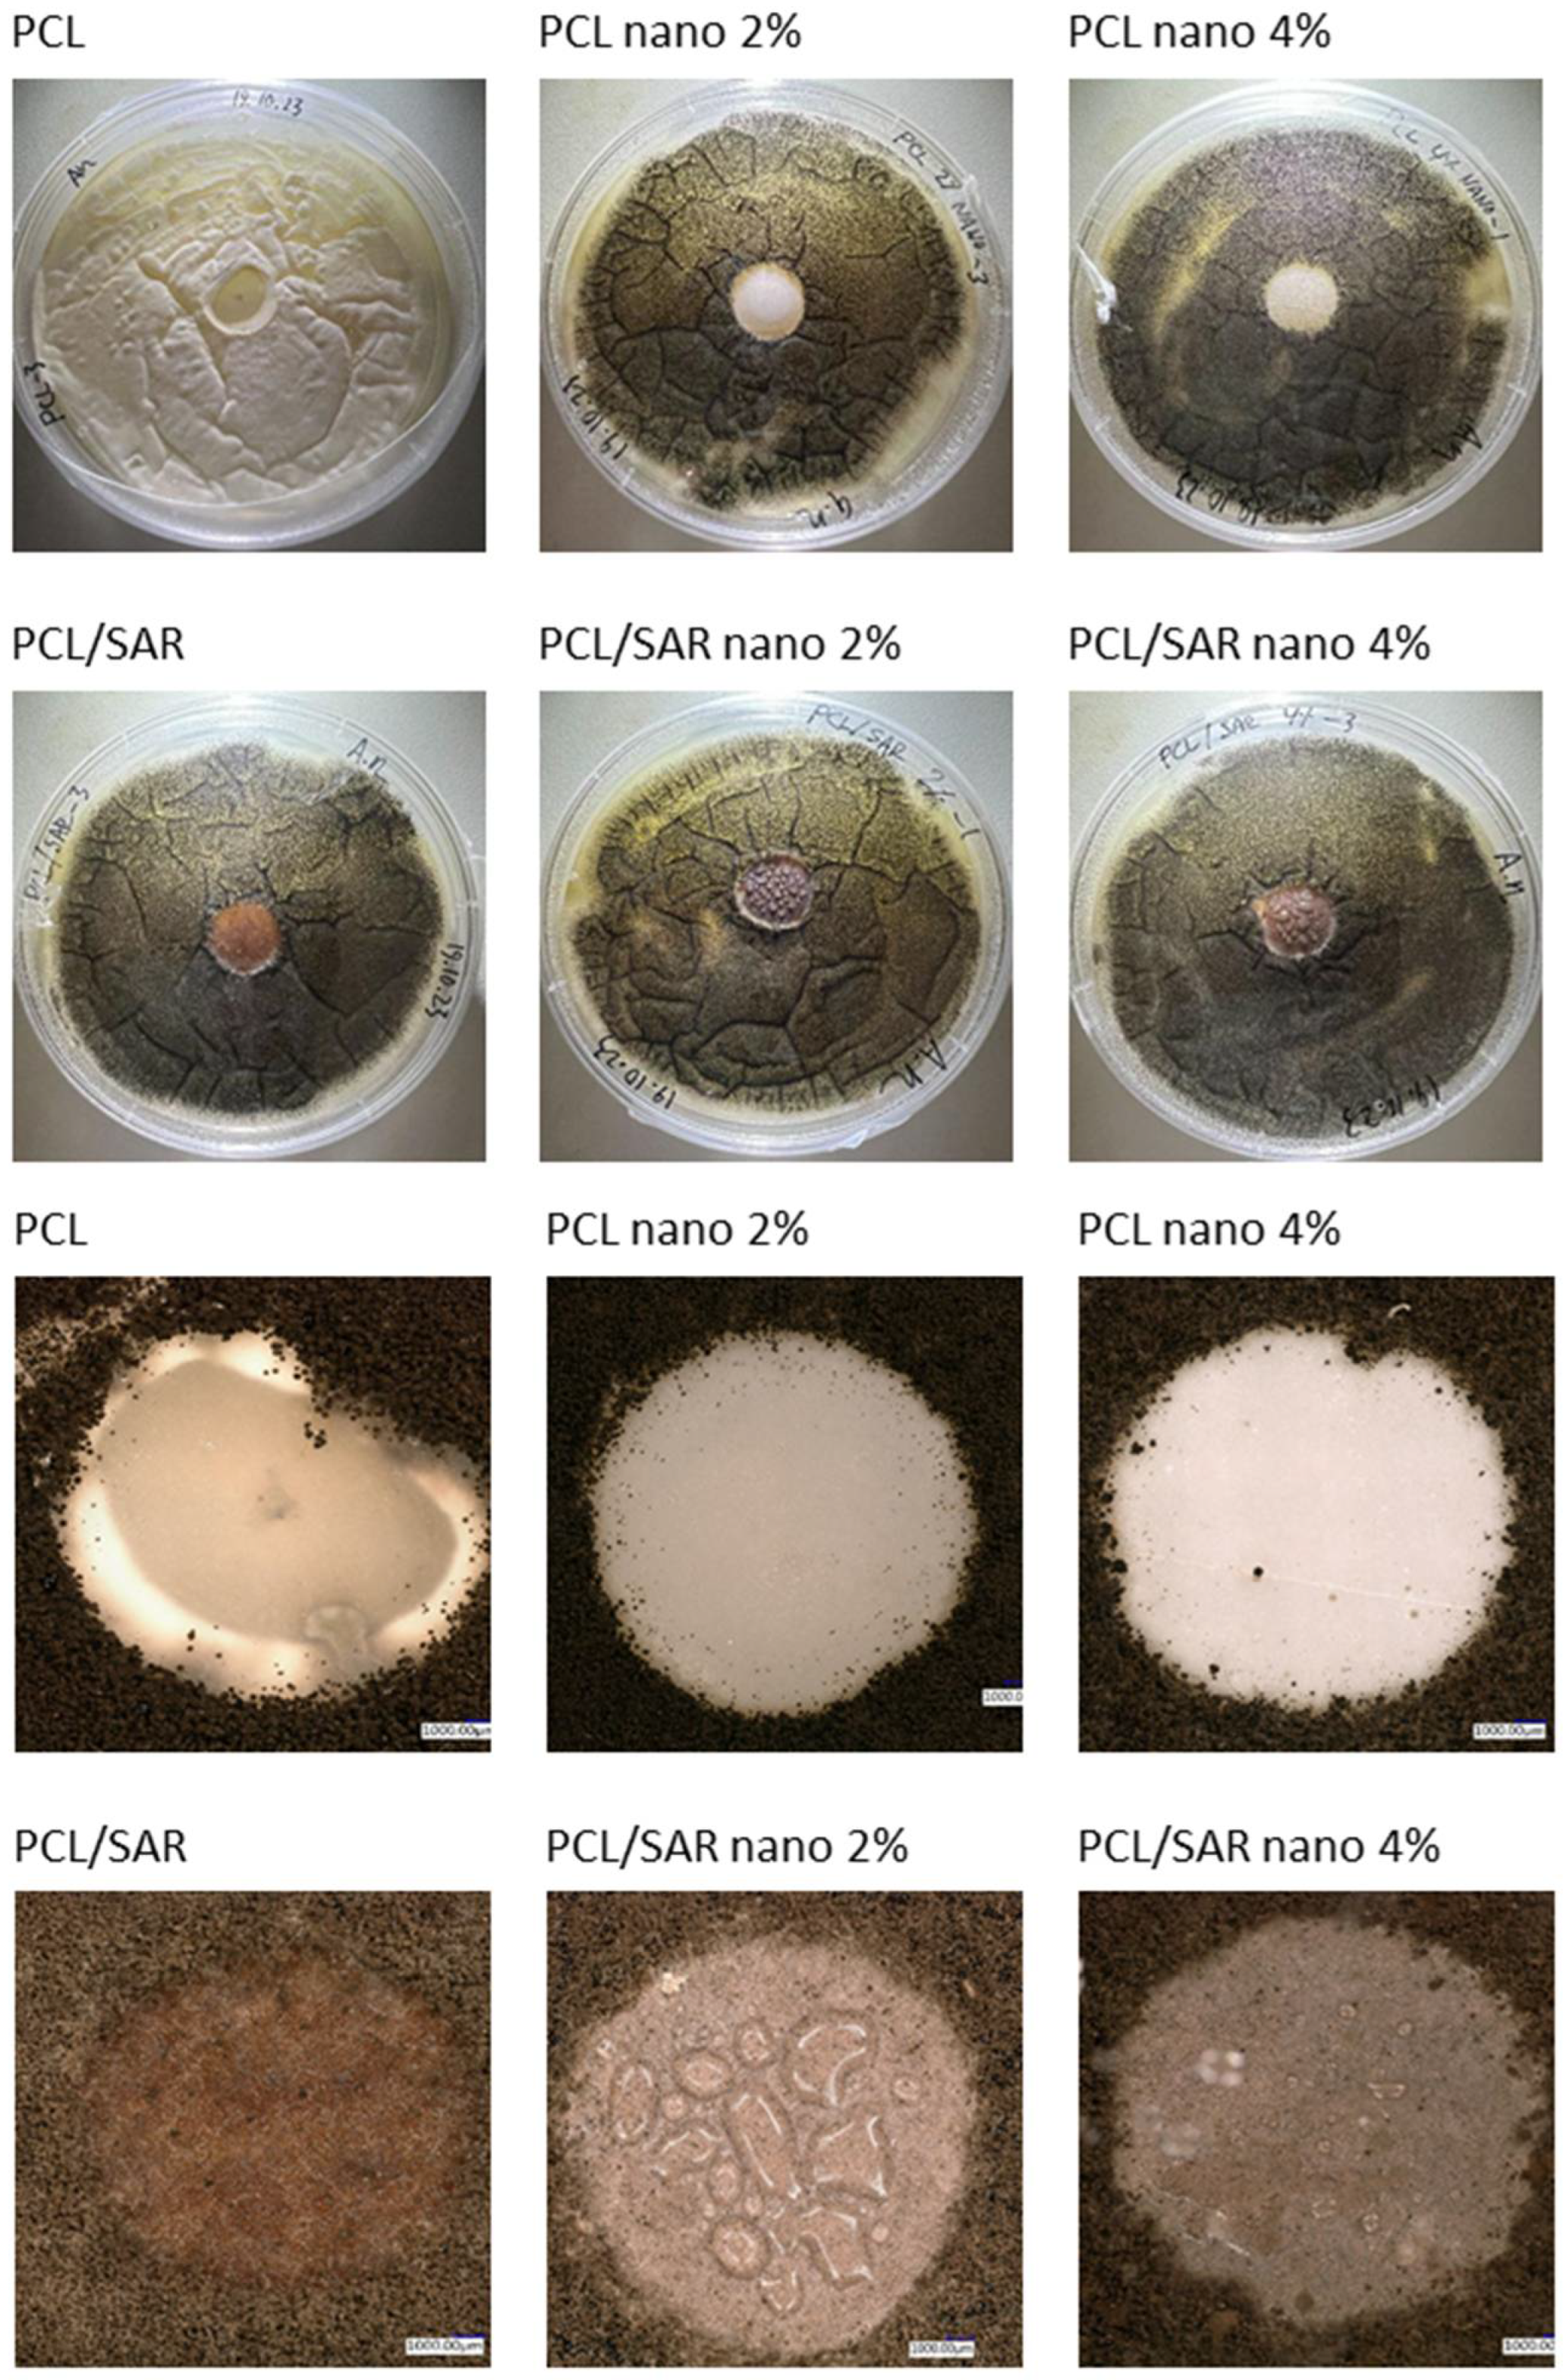
Preprints 110327 g004

1. Introduction
Surface finishing technologies in the furniture industry aim to ensure both aesthetic appeal and functional safety, including resistance to hydrolysis [
1], biological factors [
2], fire retardance [
3] and minimizing environmental emissions, depending on the furniture's intended use. Breakthroughs in green nanotechnology are revolutionizing processes and products, benefiting the environment, reducing pollution, and conserving resources [
4,
5].
Poly(lactic acid) (PLA) polymers, derived from renewable resources like corn starch or sugarcane [
6], offer an eco-friendly alternative for wood finishing coatings [
7], combining sustainability with a durable finish [
8,
9]. However, due to some drawbacks of PLA, further modifications are implemented, including fiber reinforcement [
7,
8,
9,
10,
11,
12,
13,
14,
15,
16], blending [
17] or plasticization [
18]. The findings by OKSMAN et al. indicate that PLA serves as an effective matrix material for natural fiber composites, demonstrating promising improvements in the mechanical properties of PLA and flax fiber composites [
19].
Aside of PLA, another promising biodegradable polymer is polycaprolactone (PCL), showing good compatibility with other polymers [
20,
21,
22,
23,
24,
25]. It has also been proven beneficial to incorporate lignocellulosic particles/fibers into PCL to enhance its properties [
16,
21,
26,
27] or other compounds like kaolin [
28] or bioactive glass [
29].
The incorporation of nanoparticles into polymers, also PLA and PCL, is an area of research that holds promise for enhancing the properties and functionality of these biodegradable materials. Incorporating nanoparticles like SiO
2, Al
2O
3, TiO
2, and Fe
2O
3 into Poli-L-lactide (PLLA) significantly improves the barrier properties of the resulting nanocomposites, reducing water vapour permeability by up to 18% and wet oxygen permeability by up to 9% [
30]. By applying CaCO
3 nanoparticles up to 5 wt% the gas permeability results of N
2, O
2, and CO
2 revealed an improvement in final barrier properties [
31]. CeO
2 nanoparticles deposition on wood surfaces with chitosan and cationic starch as building blocks proved to offer a significant UV protection effect while being a fully biodegradable and durable product [
32]. Also, nano-ZnO deposited on wood by KONG et al. [
33], forming dense and uniform arrays of nanorods provided UV protection, improved photostability, enhanced flame retardancy, and water repellency when modified with stearic acid. Cellulose nanocrystals (CNC) and lignin nanoparticles (LNP) enabled the creation of PVC-based composites with improved barrier properties, limiting gas migration and enhancing the UV-shielding [
34]. Incorporating nanoparticles into polymers can improve barrier properties due to two main factors: 1. reduction in available diffusion area, achieved by replacing permeable polymer with impermeable nanoparticles; 2. increased path length for the permeant to traverse the film, as it follows a convoluted route around the impermeable nanoparticles [
35].
One of the other potential improvements that the implementation of nanoparticles can bring, is making the composite bioprotective. It has been proven, that the addition of metal-based particles, such as copper [
36,
37] and silver [
15,
38,
39], into polymers is a versatile route to take advantage of their strong antimicrobial properties, producing novel biocide materials [
40]. Moreover, as WU et al. found out in the example of organoclays, the introduction of nanofillers leads to a significant enhancement in phase morphology, primarily due to their strategic localization that effectively prevents the merging of discrete domains and encourages the breakup of droplets [
25].
Carbon-rich natural substances, like those found in birch bark extraction products, such as suberic acids (SA) and their residues (SAR), have significant potential for reducing emissions of harmful substances into the environment. The findings of Jeżo and Kowaluk [
16] indicate a positive influence of 20% and 50% addition of SAR into PLA and PCL blends regarding TVOC and formaldehyde emission from plywood. This can be attributed to the high lignin content in SAR particles. Furthermore, SAR addition enhances the relative hardness and scratch resistance of PLA- and PCL-based surface finishing materials. This paper investigates whether adding nano Zinc-oxide (nano-ZnO) can improve the barrier properties and biological resistance of nanocomposites created by blending PLA/PCL, SAR, and nanoparticles. Since it has been shown, that the addition of nano-ZnO to PLA/PCL has potential in medical applications [
41,
42], it is to be found if such potential lays also in the wood composites industry. Both the effects of SAR addition and nanoparticle incorporation will be investigated.
2. Materials and Methods
2.1. Materials
Surface finishing layers were fabricated using two distinct matrices: laboratory-purpose PLA (Sigma-Aldrich, Saint Louis, MO, USA, product no. 38534) and PCL (Sigma-Aldrich, product no. 704105) in drops with a diameter of 3 mm. Suberinic acid residues (SAR) used in the research, that have been utilized to prepare the blends, have been described in detail by Rizikovs et al. [
43]. The following are the basic chemical properties of SAR: cellulose 9.0 wt%, aromatic suberin, lignin 21.4 wt%, ω-hydroxy acids 17.5%, and α, ω-diacids 11.9%. The nanoparticles used in the study were nano zinc-oxide (nano-ZnO), hereafter called “nano” obtained from ASTON Chemicals, Warsaw, Poland, with a diameter of 265 nm. Methylene chloride (CH2Cl2) (Sigma-Aldrich, product no. 34856), toluene (C6H5CH3) (Sigma-Aldrich, product no. 320552), Potato Dextrose Agar (Sigma Aldrich, product no. 70139).
2.2. Blends Processing Methods
(1) PLA finishing layer, made by mixing methylene chloride (CH2Cl2) solution for PLA, 21% dry matter content, with SAR powder, 10% w/w, respectively, hereafter called “PLA/SAR” and with nano-ZnO particles, 2% and 4%, w/w, respectively, hereafter called “PLA/SAR nano 2%” and “PLA/SAR nano 4%”. Samples with the addition of nano-ZnO but without SAR are hereafter called “PLA nano 2%” and “PLA nano 4%”. A pure PLA surface finishing layer has also been tested (hereafter called “PLA”) as a reference. All the prepared blends have been spread on Polytetrafluoroethylene (PTFE) sheets under a fume hood in order to evaporate the solvent, and then milled to attain a powder size smaller than 0.1 mm. Such a powder has been formed in a hot press (as mentioned above), as described by Gumowska et al. [
44]. The prepared film has been pressed in a hot press (pressing time 75 s, temperature 185 ◦C, and pressure 0.8 MPa) onto the unfinished particleboard surface described above.
(2) PCL finishing layer, obtained by toluene (C6H5CH3) solution for PCL, 25% dry matter content. The remaining steps of surface finishing preparation are the same as those described above for PLA. Using this method, the subsequent samples have been attained: PCL (hereafter called “PCL”; no SAR/nano-ZnO addition, reference sample) “PCL/SAR”, “PCL/SAR nano 2%”, “PCL/SAR nano 4%”, “PCL nano 2%”, “PCL nano 4%”.
According to the research plan, the surface finishing layers created on the particleboard base were exposed to ambient conditions (20 ◦C; 65% R.H.) until a constant weight was achieved over a span of seven days before tests. All the variants and their composition have been presented in
Table 1.
From each variant, one sample has been grinded and pressed on the surface twice, to investigate the effect of repeated processing on the relative hardness.
2.3. Relative Hardness
Relative hardness was measured according to the procedure described in the ISO 1522 standard [
45]. As many as 2 repetitions per tested sample type were performed.
2.4. Cold Liquids Resistance
Cold liquid resistance was measured according to the procedure described in the EN 12720+A1 standard [
46]. As many as 2 repetitions per tested sample type were performed. The following cold liquids were employed: acetone, citric acid, ethanol, and distilled water. The exposition time equaled 24 hours.
2.5. Total VOC and Formaldehyde Emission
The Total VOC and formaldehyde emission tests were completed in the emission test chamber at a temperature of 23 ◦C +/− 0.5 ◦C and relative air humidity of 44% +/− 1%. Other parameters of sample conditioning were performed following the EN 717-1 standard [
47]. The TVOC and formaldehyde emission tests were carried out after 24 h of conditioning of the samples by analyzing the chamber air over three repetitions after 20 min each using a JD-3002 Air Quality Tester (Dongguan Jinlide Electronic Technology Co., Ltd., Dongguan City, Guangdong Province, China). We adhered to the standards regarding air conditioning conditions for samples during the emission test.
2. 6. Antifungal Test
In the antifungal study, the disc diffusion method was employed to assess the growth inhibition of the materials on specific mold fungi. A 90 mm Petri dish containing Potato Dextrose Agar was centrally inoculated with a 100 µL spore suspension of two common Molds species, namely Aspergillus niger and Cladosporium cladosporioides. The spores were evenly spread using a sterile plastic spreader. Subsequently, one test disc of each type of test material was placed in the center of the plate and three replicas of each material were employed for each mold species. The plates were incubated in a growth chamber in the dark under a control temperature of 25°C. After 10 days of incubation, the growth of fungi was visually evaluated using a Keyence VHX-6000 digital microscope (Keyence, Osaka, Japan). The growth of mold was assessed based on the percentage of mold coverage on the surface. To ensure uniform evaluation of the test, the following six-grade assessment scheme was applied in this experiment:
Grade 0 = no infestation of the surface.
Grade 1 = 1–20% infestation of the surface.
Grade 2 = 21–40% infestation of the surface.
Grade 3 = 1–60% infestation of the surface.
Grade 4 = 61–80% infestation of the surface.
Grade 5= 81–100% infestation of the surface.
2.7. The Effect of Repeated Processing of Polymer Blends on Their Hardness
The samples have been pressed onto the board surface, as described in 2.1. and then subsequently recovered from the surfaces by scratching off. Then, recovered blends were ground and pressed onto the surfaces again. One sample of each type has been processed this way, and then the relative hardness has been examined as described in 2.2.
2.8. Statistical Analysis
Analysis of variance (ANOVA) and t-test calculations were used to verify significant differences (α = 0.05) between factors and levels where appropriate, using the RStudio software (R Foundation, Vienna, Austria).
3. Results and Discussion
3.1. Cold Liquids Resistance
The cold liquids resistance evaluation results of the tested surface finishing layers have been presented in
Table 2. When it comes to pure PLA, only in the case of citric acid and distilled water was there slight cloudiness found. There was no significant influence of the addition of SAR to PLA regarding the resistance to cold liquids. The pure PCL layer has been more resistant when referred to PLA. No changes in the surface have been found. The addition of SAR to PCL did not significantly lead to lowering of the resistance of the tested blends. Only in case of PCL/SAR nano 4% sample there has been slight change observed when affected by ethanol. To compare the results with the commercial coatings, let us regard waterborne coatings (acrylate-based and polyurethane-based). Pavlic
et al. [
48] found out that the best resistance to cold liquids was performed in the case of exposure to water and citric acid, while the fastest changes were observed after acetone application. The coatings that were acrylic-based performed better resistance compared to the polyurethane-based ones. It was also stated by Lis
et al. [
49] that most of the agents had caused no changes on waterborne UV acrylic coatings even after 24 h. Only the ethyl alcohol showed negative impact on evaluated surfaces, causing slight changes.
3.2. Total VOC and Formaldehyde Emission
Table 3 shows the results of testing the emission of free formaldehyde (HCHO) and (VOCs) in samples covered with coatings on both sides. A particleboard not covered with any coating was used as a control sample (REF). There has been a significant reduction of TVOC and HCHO emission when the investigated surface finishing layers have been applied. The addition of SAR reduces the revealed emissions. However, the lowest emissions values have been obtained for the samples with nano-ZnO incorporated with the PCL nano 2% and 4% performing the strongest gas barrier properties. The polymer matrix was the only significant factor in this test. The mentioned reduction of TVOC and formaldehyde emission from particleboard covered with different surface finishing layers can be an effect of the scavenger nature of lignin, which is the main component (over 21 wt%) of SAR. The SAR-containing surface finishing layers act as a bi-functional barrier layer, which can avoid the gas transfer from the core of the composite to the environment, as well as can fix the formaldehyde and other emitted compounds in the finishing layer structure [
50]. According to [
51] and [
52], the blends of PLA, as well as PCL can be recognized as extremely promising for the development of bio-based and biodegradable polymeric materials with low oxygen permeation, that is, for the development of suitable alternatives to conventional and highly pollutant oil-based plastics. It can be concluded, that the tested surface finishing materials, based on biopolymers with SAR incorporation, have promising features regarding the gas barrier layer on wood-based material surfaces. It is moreover notable, that nanoparticles exhibit great advantages since they can reduce formaldehyde emissions through indirectly increasing the curing degree of the resins, thus resulting in improved hydrolytic stability, due to the increased chemical bonds of the resin components with free formaldehyde. Furthermore, the reaction of hydroxyl groups that occur on the nanomaterial surface with free formaldehyde, and such coatings are able to perform barrier properties or “shielding effect” [
53]. As [
54] found out, the application of 8% zinc results a reduction in formaldehyde emission by an average of 44%.
2.3. Relative Hardness
The
figure 1 shows the results of testing the relative hardness of the produced coatings. In coatings made on a PLA matrix, the sample made of pure polymer without additives (0.52) showed the highest hardness. For the sample with a 2% addition of nano-ZnO, a decrease in hardness to 0.43 was observed, while when the share of nanoparticles was increased, there was a slight increase in hardness (0.45). PLA-based samples containing SAR showed significantly lower hardness, 0.33, 0.30 and 0.33 for the PLA/SAR variants, PLA/SAR nano 2% and PLA/SAR nano 4%, respectively. As for the samples produced on the basis of the PCL matrix, the pure polymer showed a hardness of 0.42. The nano-ZnO tax resulted in an increase in hardness to 0.45 and 0.47, respectively. For the PCL/SAR sample, a decrease in hardness to 0.39 was observed, while for the PCL/SAR nano 2% and PCL/SAR nano 4% variants, an increase in hardness to 0.50 and 0.48 was observed, respectively. Statistical analysis showed that in the case of the tested samples, statistically significant differences were related to the addition of SAR, the type of matrix, as well as the interaction between the matrix and SAR. The addition of nanoparticles did not have a statistically significant impact on the obtained results.
Previous research conducted by Jeżo and Kowaluk [
16] on PLA and PCL blends with SAR showed that the addition of 20% and 50% SAR causes an increase in hardness. However, [
55] stated in their study that the mechanical properties of PLA/IFR (intumescent flame retardant (IFR)-graphene oxide (GO)) blend when incorporated by nano-ZnO were diminished seriously, the tensile strength decreased by 67%, the impact strength decreased by 69% and the elongation at break was off by 70%. The authors explain their findings with nano-ZnO catalyzing PLA, which decomposed into small chains with low molecular and then was destroyed easily. Also [
56] stated that addition of ZnO nanoparticles introduced an accelerated degradation of the PLA/PCL blends. Rheological results showed that with increasing nanoparticles, the elastic modulus and the complex viscosity decreased, which was correlated to the degradation and chain scission of polymeric chains induced by nano-ZnO. The mentioned references are applicable since an approximately linear correlation between the hardness and elastic modulus has been established [
57]. Moreover, the tensile strength and the hardness of a material are highly correlated [
58]. The large size of the nanoparticles could also have influenced the negative results. As shown by [
59], big size and aggregates/agglomerates weaken the positive attributes of nanoparticles in nanocomposites. Small nanoparticles and thick interphase present high levels for the B parameter (interfacial parameter which shows the level of interfacial adhesion), tensile strength, interphase volume fraction, and an interphase parameter. [
60] confirm that by decreasing the particle size from 300 nm to 10 nm, the SiO2 nanoparticles become drastically harder (∼39×), stiffer (∼15×), and tougher (>3.5×).
Since SAR showed statistical significance for the obtained results, the decrease in hardness of samples containing PCL and PLA can also be attributed to its addition. Because improved mechanical properties, including hardness, are known from the literature after adding natural fibers to polymers [
16,
54], the authors intend to take a closer look at the observed phenomenon and link it with manufacturing parameters and further processing. The result for worsening of relative hardness by incorporation of SAR can be due to its alkaline form. It has been confirmed by [
61], that alkali treatment can cause a depolymerization of polymers. Also [
62] reported that at a lignin content of 10 wt%, heterogeneous morphology was observed, suggesting phase separation between PLA and alkali lignin. Similar observations were shown in PLA/kraft lignin blends with lignin concentrations higher than 10 wt% [
63,
64]. This heterogeneity might be an indication of weak mechanical properties of the investigated system at concentrations higher than 10 wt%.
Comparing the obtained results with different polymer matrixes, it is worth mentioning that by increasing nano-ZnO up to 0.3% in a polystyrene polymer matrix, there is a remarkable increment of approximately 47% in the hardness [
65], while the hardness can be decreased by 5.73% when added into natural rubber [
66]. Incorporation of ZnO–Ag hybrid nanoparticles into the acrylate epoxy matrix increases its pendulum hardness [
67], while compared with neat polyurethane acrylate (PUA), the hardness in films increases from 0.03 to 0.05 GPa when ZnO in share of 5% is incorporated [
68].
Degradation causes changes in mechanical properties, particularly when the molecular weight importantly decreases. Reinforcements could attenuate the loss in mechanical properties, depending on its structural integrity and the state of interfacial adhesion [
69].
Figure 1.
The results of the relative hardness of the examined coatings.
Figure 1.
The results of the relative hardness of the examined coatings.
2.4. Antifungal Test
In the
figure 2 the results of the antifungal tests have been illustrated, with demonstration of average mold grade values. In
figure 3,
figure 4,
figure 5 and
figure 6 the photos of the infected samples have been shown. In the case of samples containing PLA and additives, specifically PLA/SAR nano 2%, PLA/SAR nano 4%, and PLA nano 4%, a higher antifungal effect was observed, with no contact between the fungal spores and the material, in contrast to the PLA control. Additionally, PLA/SAR nano 2% and PLA/SAR nano 4% demonstrated an inhibition zone against A. niger, indicating their ability to prevent or impede fungal growth. Similar antifungal effects were observed in PLA samples against
C. cladosporioides, with the highest activity in samples PLA/SAR nano 2%, PLA/SAR nano 4%, and PLA nano 4%. An exception was found in PLA/SAR samples, which proved to be the most susceptible to
A. niger and
C. cladosporioides. Conversely, samples containing PCL and additives generally exhibited better performance, particularly against
C. cladosporioides, notably in samples PCL/SAR nano 4%, PCL nano 2%, and PCL nano 4%. However, even the PCL control showed some inhibitory effect against
C. cladosporioides. In the case of A. niger, PCL samples displayed similar performance in PCL/SAR nano 2%, PCL/SAR nano 4%, and PCL nano 2%, where few spores were observed, unlike the control sample (PCL) and PCL/SAR, where the samples were colonized by
A. niger.
As other studies confirm, the silane modified ZnO hybrid embedded Poly(methyl methacrylate) (PMMA) offer resistance against fungal growth when infected with
Aspergillus niger and
Aspergillus flavus [
70]. Nano-ZnO shows antifungal activity against
Aspergillus niger with an MIC of 2.5 mg/mL. Thus nano-ZnO is twice as potent in killing
Aspergillus, as compared to its non-nano-counterpart (micro ZnO) [
71].
Figure 2.
The average mold grade of the examined coatings exposed to A. niger and C. cladosporioides
Figure 2.
The average mold grade of the examined coatings exposed to A. niger and C. cladosporioides
Figure 3.
PCL tested with Cladosporium cladosporiodies
Figure 3.
PCL tested with Cladosporium cladosporiodies
Figure 4.
PCL tested with Aspergillus niger
Figure 4.
PCL tested with Aspergillus niger
Figure 5.
PLA tested with Cladosporium cladosporiodies
Figure 5.
PLA tested with Cladosporium cladosporiodies
Figure 6.
PLA tested with Aspergillus niger
Figure 6.
PLA tested with Aspergillus niger
2.5. Relative Hardness after Repeated Processing of the Samples
Figure 7 shows a comparison of the relative hardness of the tested coatings ground and pressed once and twice. A decrease in the value of the tested parameter can be noticed for samples whose coating was reprocessed after ironing. The decrease in hardness recorded for the samples is shown in the table. Greater differences were observed in the case of samples made on the basis of the PLA matrix than on the basis of the PCL matrix. As a result of the re-processing of PLA-based blends, the polymer degraded, which significantly affected its mechanical properties, an example being the loss of hardness. [
72] report similar observations for PLA blends with starch, where the degradation of PLA was confirmed by SEM tests. The authors observed a decrease in the flexural modulus and impact strength values as a result of repeated processing of the blends. The degradation of PLA due to repeated processing is also confirmed by [
73], who investigated the impact of repeated extrusion on the properties of PLA/HDPE and PLA/PC blends. As demonstrated by [
74], mechanically recycled PLA has lower mechanical properties compared to virgin PLA, with impact strength and hardness decreasing by 50% and 4%, respectively.
Although the literature lacks examples of a decrease in hardness after regrinding for PCL, researchers have considered many other polymers - polyoxymethylene (POM) [
75], thermoplastic polyurethane elastomers [
76] or polypropylene [
77] - which may confirm a similar trend for PCL as demonstrated in this study. However, there have been found polymers that increased their hardness after couple of cycles of processing, like high impact polystyrene [
78].
Statistical analysis showed statistically significant differences between the values obtained for hardness after one and two processing, which confirms that repeated grinding and pressing of polymer blends statistically reduces their relative hardness. Moreover, the only factor that had a statistically significant impact on the percentage decrease in hardness after reprocessing was the type of polymer matrix.
Table 4.
Percentage decrease of relative hardness of the examined samples after the second processing.
Table 4.
Percentage decrease of relative hardness of the examined samples after the second processing.
| Variant label |
Hardness decrease after the second pressing |
PLA
PLA nano 2%
PLA nano 4%
PLA/SAR
PLA/SAR nano 2%
PLA/SAR nano 4% |
34.60%
23.72%
26.14%
16.57%
24.62%
23.32% |
PCL
PCL nano 2%
PCL nano 4%
PCL/SAR
PCL/SAR nano 2%
PCL/SAR nano 4% |
-3.81%
13.28%
15.49%
-5.00%
24.66%
20.73% |
5. Conclusions
The following study aimed to investigate some preliminary examinations on the surface finishing coatings containing suberinic acid residues (SAR) with nano zinc-oxide (nano-ZnO). The tests performed included: resistance to cold liquids, relative hardness, formaldehyde and VOC emissions as well as antifungal tests. The results revealed no worsening when exposed to cold liquids in the case of samples based on the PCL matrix with slight changes in some samples based on PLA polymer. The relative hardness tests showed a decrease in hardness regarding PLA-based samples when incorporated nanoparticles and PCL-based samples performed a decrease in hardness in case of SAR incorporation. This phenomenon needs to be further investigated, however, the authors suggest that the reason of this worsening might have been the alkali character of the SAR incorporated. It has been concluded that the incorporation of SAR and nano-ZnO allowed to minimize both the emissions of free formaldehyde as well as TVOC. The investigated samples with fillers incorporated exhibited moreover good antimicrobial properties. Moreover, the impact of repeated processing on the relative hardness has been regarded, leading to an observation of a decrease in this parameter for both PLA and PCL. The authors see great potential in the findings obtained and the topic will be continuously investigated.
Author Contributions
Conceptualization, A.J. and G.K.; methodology, A.J, G.K., R.H. and F.P..; validation, A.J, G.K., R.H. and F.P.; formal analysis, A.J, G.K., R.H. and F.P.; investigation, A.J, G.K., R.H. and F.P.; resources, A.J, G.K., R.H. and F.P.; data curation, A.J., R.H. and F.P.; writing—original draft preparation, A.J, G.K., R.H. and F.P.; writing—review and editing, A.J. and G.K..; visualization, A.J., R.H. and F.P.; supervision, G.K. and R.H..; project administration, G.K..; funding acquisition, A.J. and G.K.. All authors have read and agreed to the published version of the manuscript.
Funding
The research presented is a part of Project BarkBuild that is funded under the ERA-NET Cofund ForestValue program through Vinnova (Sweden), Valsts izglītības attīstības aģentūra (Latvia), Ministry of Education, Science and Sport (JIA) (Slovenia), Academy of Finland, The Research Council of Norway, and the National Science Centre, Poland (contract no. 2021/03/Y/NZ9/00038). The ForestValue program received funding from the Horizon 2020 Research and Innovation program of the European Union under grant agreement No. 773324.
Institutional Review Board Statement
Not applicable.
Informed Consent Statement
Not applicable.
Data Availability Statement
The data presented in this study are available on request from the corresponding author.
Acknowledgments
The mentioned research is conducted with the support of the Student Furniture Scientific Group (Koło Naukowe Meblarstwa), Faculty of Wood Technology, Warsaw University of Life Sciences – SGGW. The authors would acknowledge Janis Rizikovs, Latvian State Institute of Wood Chemistry, Riga, Latvia, for kindly providing the bark post-extraction residues. The authors would also like to kindly thank the ASTON Chemicals Company for providing the nanoparticles for this study.
Conflicts of Interest
The authors claim no conflict of interest.
References
- Yang, L.; Wu, Y.; Yang, F.; Wang, W. The Effect of Antibacterial and Waterproof Coating Prepared From Hexadecyltrimethoxysilane and Nano-Titanium Dioxide on Wood Properties. Front. Mater. 2021, 8, 1–8. [Google Scholar] [CrossRef]
- Tracton, A.A. Coatings Technology Handbook, 3rd Edition, Chapter 83: Fluorocarbon Resins for Coatings and Inks.; 2005; ISBN 1574446495.
- Kozlowski, R.; Wesolek, D.; Wladyka-Przybylak, M. Combustibility and Toxicity of Board Materials Used for Interior Fittings and Decorations. Polym. Degrad. Stab. 1999, 64, 595–600. [Google Scholar] [CrossRef]
- Eric, J. Bailey, K.I.W. Dynamics of Polymer Segments, Polymer Chains, and Nanoparticles in Polymer Nanocomposite Melts: A Review. Prog. Polym. Sci. 2020, 105. [Google Scholar] [CrossRef]
- Jurate Virkutyte; Rajender S. Varma Green Synthesis of Metal Nanoparticles: Biodegradable Polymers and Enzymes in Stabilization and Surface Functionalization. Chem. Sci. 2011, 2, 837–846. [Google Scholar] [CrossRef]
- Vaidya, A.N.; Pandey, R.A.; Mudliar, S.; Kumar, M.S.; Chakrabarti, T.; Devotta, S. Production and Recovery of Lactic Acid for Polylactide - An Overview. Crit. Rev. Environ. Sci. Technol. 2005, 35, 429–467. [Google Scholar] [CrossRef]
- Valerga, A.P.; Batista, M.; Fernandez-Vidal, S.R.; Gamez, A.J. Impact of Chemical Post-Processing in Fused Deposition Modelling (FDM) on Polylactic Acid (PLA) Surface Quality and Structure. Polymers (Basel). 2019, 11. [Google Scholar] [CrossRef]
- A. Jordá-Vilaplana, V. Fombuena, D. García-García, M.D. Samper, L.S.-N. Surface Modification of Polylactic Acid (PLA) by Air Atmospheric Plasma Treatment. Eur. Polym. J. 2014, 58, 23–33. [Google Scholar] [CrossRef]
- Jin, Y.; Wan, Y.; Zhang, B.; Liu, Z. Modeling of the Chemical Finishing Process for Polylactic Acid Parts in Fused Deposition Modeling and Investigation of Its Tensile Properties. J. Mater. Process. Technol. 2017, 240, 233–239. [Google Scholar] [CrossRef]
- Lv, S.; Gu, J.; Tan, H.; Zhang, Y. The Morphology, Rheological, and Mechanical Properties of Wood Flour/Starch/Poly(Lactic Acid) Blends. J. Appl. Polym. Sci. 2017, 134, 1–9. [Google Scholar] [CrossRef]
- Lv, S.; Zhang, Y.; Gu, J.; Tan, H. Biodegradation Behavior and Modelling of Soil Burial Effect on Degradation Rate of PLA Blended with Starch and Wood Flour. Colloids Surfaces B Biointerfaces 2017, 159, 800–808. [Google Scholar] [CrossRef]
- Khoo, R.Z.; Chow, W.S. Mechanical and Thermal Properties of Poly(Lactic Acid)/Sugarcane Bagasse Fiber Green Composites. J. Thermoplast. Compos. Mater. 2017, 30, 1091–1102. [Google Scholar] [CrossRef]
- Müller, K.; Van Opdenbosch, D.; Zollfrank, C. Cellulose Blends with Polylactic Acid or Polyamide 6 from Solution Blending: Microstructure and Polymer Interactions. Mater. Today Commun. 2022, 30, 103074. [Google Scholar] [CrossRef]
- Serra-Parareda, F.; Delgado-Aguilar, M.; Espinach, F.X.; Mutjé, P.; Boufi, S.; Tarrés, Q. Sustainable Plastic Composites by Polylactic Acid-Starch Blends and Bleached Kraft Hardwood Fibers. Compos. Part B Eng. 2022, 238. [Google Scholar] [CrossRef]
- Ghasemzadeh, H.; Ghanaat, F. Antimicrobial Alginate/PVA Silver Nanocomposite Hydrogel, Synthesis and Characterization. J. Polym. Res. 2014, 21. [Google Scholar] [CrossRef]
- Jeżo, A.; Kowaluk, G. Carbon Capture and Storage through Upcycling of Suberinic Acid Residues in Wood Composites Finishing. C-Journal Carbon Res. 2023, 9. [Google Scholar] [CrossRef]
- Li, Y.; Shimizu, H. Toughening of Polylactide by Melt Blending with a Biodegradable Poly(Ether)Urethane Elastomer. Macromol. Biosci. 2007, 7, 921–928. [Google Scholar] [CrossRef] [PubMed]
- Martin, O.; Avérous, L. Poly(Lactic Acid): Plasticization and Properties of Biodegradable Multiphase Systems. Polymer (Guildf). 2001, 42, 6209–6219. [Google Scholar] [CrossRef]
- Oksman, K.; Skrifvars, M.; Selin, J.F. Natural Fibres as Reinforcement in Polylactic Acid (PLA) Composites. Compos. Sci. Technol. 2003, 63, 1317–1324. [Google Scholar] [CrossRef]
- Sousa, F.M.; Costa, A.R.M.; Reul, L.T.A.; Cavalcanti, F.B.; Carvalho, L.H.; Almeida, T.G.; Canedo, E.L. Rheological and Thermal Characterization of PCL/PBAT Blends. Polym. Bull. 2019, 76, 1573–1593. [Google Scholar] [CrossRef]
- de Campos, A.; Tonoli, G.H.D.; Marconcini, J.M.; Mattoso, L.H.C.; Klamczynski, A.; Gregorski, K.S.; Wood, D.; Williams, T.; Chiou, B. Sen; Imam, S.H. TPS/PCL Composite Reinforced with Treated Sisal Fibers: Property, Biodegradation and Water-Absorption. J. Polym. Environ. 2013, 21, 1–7. [Google Scholar] [CrossRef]
- Cabedo, L.; Feijoo, J.L.; Villanueva, M.P.; Lagarón, J.M.; Giménez, E. Optimization of Biodegradable Nanocomposites Based on APLA/PCL Blends for Food Packaging Applications. Macromol. Symp. 2006, 233, 191–197. [Google Scholar] [CrossRef]
- Todo, M.; Park, S.D.; Takayama, T.; Arakawa, K. Fracture Micromechanisms of Bioabsorbable PLLA/PCL Polymer Blends. Eng. Fract. Mech. 2007, 74, 1872–1883. [Google Scholar] [CrossRef]
- Fortelny, I.; Ujcic, A.; Fambri, L.; Slouf, M. Phase Structure, Compatibility, and Toughness of PLA/PCL Blends: A Review. Front. Mater. 2019, 6, 1–13. [Google Scholar] [CrossRef]
- Wu, D.; Lin, D.; Zhang, J.; Zhou, W.; Zhang, M.; Zhang, Y.; Wang, D.; Lin, B. Selective Localization of Nanofillers: Effect on Morphology and Crystallization of PLA/PCL Blends. Macromol. Chem. Phys. 2011, 212, 613–626. [Google Scholar] [CrossRef]
- da Silva, W.A.; Luna, C.B.B.; de Melo, J.B. da C.A.; Araújo, E.M.; Filho, E.A. dos S.; Duarte, R.N.C. Feasibility of Manufacturing Disposable Cups Using PLA/PCL Composites Reinforced with Wood Powder. J. Polym. Environ. 2021, 29, 2932–2951. [Google Scholar] [CrossRef]
- Barreto Luna, C.B.; dos Santos Filho, E.A.; Siqueira, D.D.; de Souza, D.D.; Ramos Wellen, R.M.; Araújo, E.M. Jatobá Wood Flour: An Alternative for the Production of Ecological and Sustainable PCL Biocomposites. J. Compos. Mater. 2022, 56, 3835–3850. [Google Scholar] [CrossRef]
- Filho, E.A.S.; Luna, C.B.B.; Silva, A.L.; Ferreira, E.S.B.; Araújo, E.M.; Costa, A.C.F.M. Effect of Kaolin Waste Annealing on the Structural and Thermal Behavior of Poly(Ε−Caprolactone). Momento 2022, 2022, 66–84. [Google Scholar] [CrossRef]
- Liverani, L.; Lacina, J.; Roether, J.A.; Boccardi, E.; Killian, M.S.; Schmuki, P.; Schubert, D.W.; Boccaccini, A.R. Incorporation of Bioactive Glass Nanoparticles in Electrospun PCL/Chitosan Fibers by Using Benign Solvents. Bioact. Mater. 2018, 3, 55–63. [Google Scholar] [CrossRef] [PubMed]
- Lizundia, E.; Vilas, J.L.; Sangroniz, A.; Etxeberria, A. Light and Gas Barrier Properties of PLLA/Metallic Nanoparticles Composite Films. Eur. Polym. J. 2017, 91, 10–20. [Google Scholar] [CrossRef]
- Aframehr, W.M.; Molki, B.; Heidarian, P.; Behzad, T.; Sadeghi, M.; Bagheri, R. Effect of Calcium Carbonate Nanoparticles on Barrier Properties and Biodegradability of Polylactic Acid. Fibers Polym. 2017, 18, 2041–2048. [Google Scholar] [CrossRef]
- Janesch, J.; Czabany, I.; Hansmann, C.; Mautner, A.; Rosenau, T.; Gindl-Altmutter, W. Transparent Layer-by-Layer Coatings Based on Biopolymers and CeO2 to Protect Wood from UV Light. Prog. Org. Coatings 2020, 138, 105409. [Google Scholar] [CrossRef]
- Kong, L.; Tu, K.; Guan, H.; Wang, X. Growth of High-Density ZnO Nanorods on Wood with Enhanced Photostability, Flame Retardancy and Water Repellency. Appl. Surf. Sci. 2017, 407, 479–484. [Google Scholar] [CrossRef]
- Yang, W.; Qi, G.; Kenny, J.M.; Puglia, D.; Ma, P. Effect of Cellulose Nanocrystals and Lignin Nanoparticles on Mechanical, Antioxidant and Water Vapour Barrier Properties of Glutaraldehyde Crosslinked PVA Films. Polymers (Basel). 2020, 12. [Google Scholar] [CrossRef]
- N. Lepot, M. K. Van Bael, H. Van den Rul, J. D’Haen, R. Peeters, D. Franco, J.M. Influence of Incorporation of ZnO Nanoparticles and Biaxial Orientation on Mechanical and Oxygen Barrier Properties of Polypropylene Films for Food Packaging Applications. J. Appl. Polym. Sci. 2011, 120, 1616–1623. [Google Scholar] [CrossRef]
- Ren, G.; Hu, D.; Cheng, E.W.C.; Vargas-Reus, M.A.; Reip, P.; Allaker, R.P. Characterisation of Copper Oxide Nanoparticles for Antimicrobial Applications. Int. J. Antimicrob. Agents 2009, 33, 587–590. [Google Scholar] [PubMed]
- Delgado, K.; Quijada, R.; Palma, R.; Palza, H. Polypropylene with Embedded Copper Metal or Copper Oxide Nanoparticles as a Novel Plastic Antimicrobial Agent. Lett. Appl. Microbiol. 2011, 53, 50–54. [Google Scholar] [PubMed]
- Palomba, M.; Carotenuto, G.; Cristino, L.; Di Grazia, M.A.; Nicolais, F.; De Nicola, S. Activity of Antimicrobial Silver Polystyrene Nanocomposites. J. Nanomater. 2012, 2012. [Google Scholar] [CrossRef]
- Thomas, V.; Yallapu, M.M.; Sreedhar, B.; Bajpai, S.K. A Versatile Strategy to Fabricate Hydrogel-Silver Nanocomposites and Investigation of Their Antimicrobial Activity. J. Colloid Interface Sci. 2007, 315, 389–395. [Google Scholar] [CrossRef]
- Palza, H. Antimicrobial Polymers with Metal Nanoparticles. Int. J. Mol. Sci. 2015, 16, 2099–2116. [Google Scholar] [CrossRef]
- Castro, J.I.; Araujo-Rodríguez, D.G.; Valencia-Llano, C.H.; López Tenorio, D.; Saavedra, M.; Zapata, P.A.; Grande-Tovar, C.D. Biocompatibility Assessment of Polycaprolactone/Polylactic Acid/Zinc Oxide Nanoparticle Composites under In Vivo Conditions for Biomedical Applications. Pharmaceutics 2023, 15, 2196. [Google Scholar] [CrossRef]
- Tian, J.; Paterson, T.E.; Zhang, J.; Li, Y.; Ouyang, H.; Asencio, I.O.; Hatton, P. V; Zhao, Y.; Li, Z. Enhanced Antibacterial Ability of Electrospun PCL Scaffolds Incorporating ZnO Nanowires. Int. J. Mol. Sci. 2023, 24, 14420. [Google Scholar] [CrossRef] [PubMed]
- Makars, R.; Rizikovs, J.; Godina, D.; Paze, A.; Merijs-Meri, R. Utilization of Suberinic Acids Containing Residue as an Adhesive for Particle Boards. Polymers (Basel). 2022, 14. [Google Scholar] [CrossRef]
- Gumowska, A.; Kowaluk, G. Physical and Mechanical Properties of High-Density Fiberboard Bonded with Bio-Based Adhesives. Forests 2023, 14. [Google Scholar] [CrossRef]
- ISO 1522 Paints and Varnishes — Pendulum Damping Test; European Committee for Standardization, Brussels, Belgium, 2022.
- EN 12720+A1 Furniture - Assessment of Surface Resistance to Cold Liquids; European Committee for Standardization, Brussels, Belgium, 2013.
- EN 717-1 Wood-Based Panels - Determination of Formaldehyde Release - Part 1: Formaldehyde Emission by the Chamber Method; European Committee for Standardization, Brussels, Belgium, 2004.
- Pavlič, M.; Petrič, M.; Žigon, J. Interactions of Coating and Wood Flooring Surface System Properties. Coatings 2021, 11, 1–13. [Google Scholar] [CrossRef]
- Lis, B. , Krystofiak T., P.S. Studies of the Resistance upon Some Factors of UV Acrylic Lacquer Coatings on MDF Boards. Part I. Resistance of Heat and Cold Liquid Action. Ann. Warsaw Univ. Life Sci. - SGGW. For. Wood Technol. 2010, 71, 450–453. [Google Scholar]
- Eom, Y.-G.; Kim, J.-S.; Kim, S.; Kim, J.-A.; Kim, H.J. Reduction of Formaldehyde Emission from Particleboards by Bio Scavengers. Mokchae Konghak 2006, 34, 29–41. [Google Scholar]
- Aversa, C.; Barletta, M.; Puopolo, M.; Vesco, S. Cast Extrusion of Low Gas Permeability Bioplastic Sheets in PLA/PBS and PLA/PHB Binary Blends. Polym. Technol. Mater. 2020, 59, 231–240. [Google Scholar] [CrossRef]
- Sousa, F.M.; Cavalcanti, F.B.; Marinho, V.A.D.; Morais, D.D.S.; Almeida, T.G.; Carvalho, L.H. Effect of Composition on Permeability, Mechanical Properties and Biodegradation of PBAT/PCL Blends Films. Polym. Bull. 2022, 79, 5327–5338. [Google Scholar] [CrossRef]
- Lykidis, C. Formaldehyde Emissions from Wood-Based Composites: Effects of Nanomaterials. Taghiyari, H.R., Morrell, J.J., Husen, A. Emerg. Nanomater. Springer, Cham. [CrossRef]
- Pinchevska, O.; Lopatko, K.; Lopatko, L.; Oliynyk, R.; Sedliačik, J. The Effect of Metal Nanoparticles on Formaldehyde Emission From Wood Based Materials. Acta Fac. Xylologiae Zvolen 2023, 65, 35–43. [Google Scholar] [CrossRef]
- Chen, Y.; Xu, L.; Wu, X.; Xu, B. The Influence of Nano ZnO Coated by Phosphazene/Triazine Bi-Group Molecular on the Flame Retardant Property and Mechanical Property of Intumescent Flame Retardant Poly (Lactic Acid) Composites. Thermochim. Acta 2019, 679. [Google Scholar] [CrossRef]
- Ahmadzadeh, Y.; Babaei, A.; Goudarzi, A. Assessment of Localization and Degradation of ZnO Nano-Particles in the PLA/PCL Biocompatible Blend through a Comprehensive Rheological Characterization. Polym. Degrad. Stab. 2018, 158, 136–147. [Google Scholar] [CrossRef]
- Rebholz, C.; Leyland, A.; Matthews, A.; Charitidis, C.; Logothetidis, S.; Schneider, D. Correlation of Elastic Modulus, Hardness and Density for Sputtered TiAlBN Thin Films. Thin Solid Films 2006, 514, 81–86. [Google Scholar] [CrossRef]
- Tien, C.-K.C.; Tzu, L. The Indirect Measurement of Tensile Strength by the Deterministic Grey Dynamic Model DGDM(1, 1, 1). Int. J. Syst. Sci. 1997, 28, 683–690. [Google Scholar] [CrossRef]
- Ashraf, M.A.; Peng, W.; Zare, Y.; Rhee, K.Y. Effects of Size and Aggregation/Agglomeration of Nanoparticles on the Interfacial/Interphase Properties and Tensile Strength of Polymer Nanocomposites. Nanoscale Res. Lett. 2018, 13. [Google Scholar] [CrossRef]
- Lu An, Di Zhang, L. Z. and G.F. Effect of Nanoparticle Size on the Mechanical Properties of Nanoparticle Assemblies. Nanoscale 2019, 11, 9563–9573. [Google Scholar] [CrossRef]
- Aydın, M.; Tozlu, H.; Kemaloglu, S.; Aytac, A.; Ozkoc, G. Effects of Alkali Treatment on the Properties of Short Flax Fiber-Poly(Lactic Acid) Eco-Composites. J. Polym. Environ. 2011, 19, 11–17. [Google Scholar] [CrossRef]
- Bužarovska, A.; Blazevska-Gilev, J.; Pérez-Martnez, B.T.; Balahura, L.R.; Pircalabioru, G.G.; Dinescu, S.; Costache, M. Poly(l-Lactic Acid)/Alkali Lignin Composites: Properties, Biocompatibility, Cytotoxicity and Antimicrobial Behavior. J. Mater. Sci. 2021, 56, 13785–13800. [Google Scholar] [CrossRef]
- Gkartzou, E.; Koumoulos, E.P.; Charitidis, C.A. Production and 3D Printing Processing of Bio-Based Thermoplastic Filament. Manuf. Rev. 2017, 4. [Google Scholar] [CrossRef]
- Park, C.W.; Youe, W.J.; Kim, S.J.; Han, S.Y.; Park, J.S.; Lee, E.A.; Kwon, G.J.; Kim, Y.S.; Kim, N.H.; Lee, S.H. Effect of Lignin Plasticization on Physico-Mechanical Properties of Lignin/Poly(Lactic Acid) Composites. Polymers (Basel). 2019, 11, 1–12. [Google Scholar] [CrossRef]
- Mohammad Azad Alam, H. H. Ya, P. B. Hussain, M. Azeem, S. M. Sapuan, Rehan khan, T.A. Experimental Investigations on the Surface Hardness of Synthesized Polystyrene/ZnO Nanocomposites. In Proceedings of the Emamian, S.S., Awang, M., Yusof, F. (eds) Advances in Manufacturing Engineering. Lecture Notes in Mechanical Engineering. Springer, Singapore.; 2020. 345–352.
- Hadi, F.A.; Kadhim, R.G. A Study of the Effect of Nano Zinc Oxide on Cure Characteristics and Mechanical Properties of Rubber Composites. J. Phys. Conf. Ser. 2019, 1234. [Google Scholar] [CrossRef]
- Nguyen, T.V.; Do, T.V.; Ngo, T.D.; Nguyen, T.A.; Lu, L.T.; Vu, Q.T.; Thi, L.P.; Tran, D.L. Photocurable Acrylate Epoxy/ZnO-Ag Nanocomposite Coating: Fabrication, Mechanical and Antibacterial Properties. RSC Adv. 2022, 12, 23346–23355. [Google Scholar] [CrossRef]
- Kim, D.; Jeon, K.; Lee, Y.; Seo, J.; Seo, K.; Han, H.; Khan, S. Preparation and Characterization of UV-Cured Polyurethane Acrylate/ZnO Nanocomposite Films Based on Surface Modified ZnO. Prog. Org. Coatings 2012, 74, 435–442. [Google Scholar] [CrossRef]
- González-López, M.E.; Martín del Campo, A.S.; Robledo-Ortíz, J.R.; Arellano, M.; Pérez-Fonseca, A.A. Accelerated Weathering of Poly(Lactic Acid) and Its Biocomposites: A Review. Polym. Degrad. Stab. 2020, 179. [Google Scholar] [CrossRef]
- Soumya, S.; Kumar, S.N.; Mohamed, A.P.; Ananthakumar, S. Silanated Nano ZnO Hybrid Embedded PMMA Polymer Coatings on Cotton Fabrics for Near-IR Reflective, Antifungal Cool-Textiles. New J. Chem. 2016, 40, 7210–7221. [Google Scholar] [CrossRef]
- Gondal, M.A.; Alzahrani, A.J.; Randhawa, M.A.; Siddiqui, M.N. Morphology and Antifungal Effect of Nano-ZnO and Nano-Pd-Doped Nano-ZnO against Aspergillus and Candida. J. Environ. Sci. Heal. - Part A Toxic/Hazardous Subst. Environ. Eng. 2012, 47, 1413–1418. [Google Scholar] [CrossRef]
- Humeyra Celik, Basak Tuna, G. O. The Effects of Thermomechanical Cycles on the Properties of PLA/TPS Blends. Adv. Polym. Technol. 2014, 33. [Google Scholar] [CrossRef]
- Yarahmadi, N.; Jakubowicz, I.; Enebro, J. Polylactic Acid and Its Blends with Petroleum-Based Resins: Effects of Reprocessing and Recycling on Properties. J. Appl. Polym. Sci. 2016, 133, 1–9. [Google Scholar] [CrossRef]
- Budin, S.; Maideen, N.C.; Koay, M.H.; Ibrahim, D.; Yusoff, H. A Comparison Study on Mechanical Properties of Virgin and Recycled Polylactic Acid (PLA). J. Phys. Conf. Ser. 2019, 1349. [Google Scholar] [CrossRef]
- Archodoulaki, V.M.; Lüftl, S.; Koch, T.; Seidler, S. Property Changes in Polyoxymethylene (POM) Resulting from Processing, Ageing and Recycling. Polym. Degrad. Stab. 2007, 92, 2181–2189. [Google Scholar] [CrossRef]
- Smorawska, J.; Włoch, M.; Głowińska, E. Structure–Property Relationship and Multiple Processing Studies of Novel Bio-Based Thermoplastic Polyurethane Elastomers. Materials (Basel). 2023, 16. [Google Scholar] [CrossRef]
- da Costa, H.M.; Ramos, V.D.; de Oliveira, M.G. Degradation of Polypropylene (PP) during Multiple Extrusions: Thermal Analysis, Mechanical Properties and Analysis of Variance. Polym. Test. 2007, 26, 676–684. [Google Scholar] [CrossRef]
- El Bhilat, H.; El Had, K.; Salmi, H.; Hachim, A. Thermo-Mechanical Characterization of Post-Consumer Recycled High Impact Polystyrene from Disposable Cups: Influence of the Number of Processing Cycles. J. Comput. Appl. Res. Mech. Eng. 2021, 10, 427–436. [Google Scholar] [CrossRef]
|
Disclaimer/Publisher’s Note: The statements, opinions and data contained in all publications are solely those of the individual author(s) and contributor(s) and not of MDPI and/or the editor(s). MDPI and/or the editor(s) disclaim responsibility for any injury to people or property resulting from any ideas, methods, instructions or products referred to in the content. |
© 2024 by the authors. Licensee MDPI, Basel, Switzerland. This article is an open access article distributed under the terms and conditions of the Creative Commons Attribution (CC BY) license (http://creativecommons.org/licenses/by/4.0/).